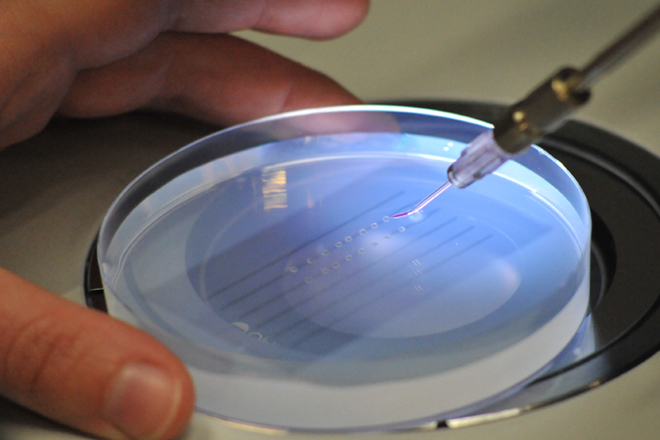

Industrie und Fotografie: die Arbeit in beiden Bereichen, setzt technisches Wissen voraus. Aber eine spezielle Kreativität ist nötig, um die Technik verständlich ins Bild zu setzen.
Mein Ziel in der Industriefotografie ist, die Kernaussagen über die Produkte in einem besonderen Zusammenhang darzustellen, und sie so verständlich und interessant zu präsentieren.